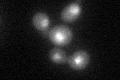
YEL019C
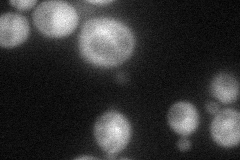
YEL019C
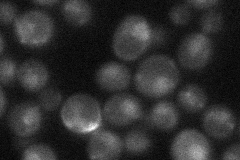
YEL019C
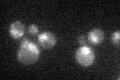
YEL019C
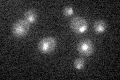
YEL019C

View description
SUMO ligase involved in chromosomal organization and DNA repair; essential subunit of the Mms21-Smc5-Smc6 complex; mutants are sensitive to methyl methanesulfonate and show increased spontaneous mutation and mitotic recombination
Localization:
Intensity:
Fold change:
Significance:
-
C’ GFP library in SD
nucleus28.97 -
N' NOP1pr-GFP in SD
cytosol52.7958 -
N' TEF2pr-mCherry in SD

cytosol29.3009 -
N' NATIVEpr-GFP in SD
nucleus27.9322 -
N' TEF2pr-VC and Cyto-VN in SD

cytosol31.5408 -
C’ GFP library in SD+DTT

nucleus28.890.99No -
C’ GFP library in SD+H2O2
nucleus28.860.99No -
C’ GFP library in Starvation Media
nucleus19.710.68Yes -
C’ GFP library on the background of Pup2-DaMP

nucleus -
C’ GFP library on the background of CCT mutant

nucleus34.84621.20246No
